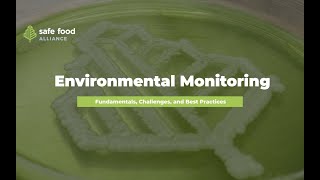
Environmental Monitoring - A Comprehensive Guide

Contaminated Sites and Historical Liability
Enroll to start learning
You’ve not yet enrolled in this course. Please enroll for free to listen to audio lessons, classroom podcasts and take practice test.
Interactive Audio Lesson
Listen to a student-teacher conversation explaining the topic in a relatable way.
Introduction to NAPLs
🔒 Unlock Audio Lesson
Sign up and enroll to listen to this audio lesson

Today, we are going to understand the behavior of non-aqueous phase liquids in sediment systems, particularly focusing on DNAPLs and LNAPLs. Can anyone tell me what NAPL stands for?

Yes, it stands for Non-Aqueous Phase Liquid.

Exactly! There are two types: DNAPLs, which are denser than water, and LNAPLs, which are lighter. Do you remember what happens to them when there is a contamination event?

DNAPLs sink while LNAPLs float.

Great! DNAPLs can settle on sediments, which complicates their remediation due to their interactions with sediment. What do you think happens to the contaminant once it has settled?

It could dissolve in the water or stay stuck in the sediment.

That's right! The dissolution and diffusion processes play a crucial role in how these contaminants spread. Let’s remember: 'Dissolve to Diffuse' as our acronym to think of these processes. Can anyone explain what 'Dissolve to Diffuse' means?

It means contaminants first dissolve into the water and then diffuse through it.

Exactly! Well done, everyone!
The Process of Contamination
🔒 Unlock Audio Lesson
Sign up and enroll to listen to this audio lesson

Now, let's look more closely at how contaminants move from sediment into water. What can cause that contamination spread?

It can spread due to diffusion, right?

Correct! That's one mechanism. But we also have to consider factors like concentration gradients and the time it takes for these processes, especially in the presence of water. Remember: 'Concentration Drives Diffusion.'

So, if there's a higher concentration of contaminants in the sediment, they will naturally move to where the concentration is lower in the water?

Exactly! And remember, this process is slow, leading to long-term contamination. Can you think of the implications of historical liabilities from this kind of contamination?

Yes, if contaminants are from years back, it can be hard to track who is responsible for cleanup.

Very insightful! Now, let’s summarize: 'Contamination is Historical.' This reminds us of the residual effects of past actions.
Historical Liability
🔒 Unlock Audio Lesson
Sign up and enroll to listen to this audio lesson

Let's shift our focus to historical liability – what does this term mean in our context?

It refers to the responsibility for past contaminations that are still affecting the environment.

Well put! Now, can anyone think of challenges that arise from such liabilities?

Finding the responsible parties can be difficult if they no longer exist.

Correct! This is a major hurdle in environmental remediation. Let's remember: 'Legacy of Contamination, Legacy of Liability.' Can someone explain what this means?

It means past contamination affects the current responsibility to clean it up, regardless of who caused it.

Exactly! To conclude today's lesson, remember that understanding historical contamination is vital for addressing current environmental challenges.
Introduction & Overview
Read summaries of the section's main ideas at different levels of detail.
Quick Overview
Standard
The section elaborates on the behaviors of dense non-aqueous phase liquids (DNAPLs) and light non-aqueous phase liquids (LNAPLs) in sediment-water systems. It emphasizes the slow processes of dissolution, diffusion, and historical contamination leading to contemporary liability issues for cleanup efforts.
Detailed
Contaminated Sites and Historical Liability
This section focuses on the interaction between sediments and various liquid contaminants, primarily categorized into dense non-aqueous phase liquids (DNAPLs) and light non-aqueous phase liquids (LNAPLs). DNAPLs, which are denser than water, tend to sink and lodge themselves into the sediment, while LNAPLs float on the water's surface. The discussion includes mechanisms by which contaminants dissolve and diffuse into sediments, illustrating the complexity of these processes through time – a significance that influences environmental remediation and regulatory responsibilities.

The narrative emphasizes the historical aspect of contamination, noting that many polluted sites are remnants of industrial practices from decades past, often associated with negligence and lack of regulation at the time of disposal. The concept of historical liability arises from this context, where responsible parties may no longer exist, leading to challenges in accountability and remediation. The section concludes with an examination of the need to model flux from contaminated sediments to surrounding water, consolidating the theme of understanding contamination for effective environmental management.
Youtube Videos

Audio Book
Dive deep into the subject with an immersive audiobook experience.
Understanding Contaminated Sediments
Chapter 1 of 4
🔒 Unlock Audio Chapter
Sign up and enroll to access the full audio experience
Chapter Content
Contamination has occurred over a period of time, water has been contaminated, and all the pure chemical that was once present has disappeared. Chemicals either dissolve into the water or attach themselves to the sediment, leading to different concentrations of contaminants as a function of depth.
Detailed Explanation
This chunk explains how sediment can become contaminated over time. Initially, there might be a chemical spill, and as time passes, the concentration of the original chemical in the water decreases as it dissolves or attaches to sediments. Different layers of sediment will have varying contaminant levels, which can complicate cleanup efforts. It emphasizes the slow, often unnoticed process of contamination and how it can lead to long-term environmental issues.
Examples & Analogies
Imagine a sponge absorbing a small amount of oil. Over time, the sponge takes in more and more oil, making it heavier and darker. Even when you wash the sponge, some oil still remains. Similarly, in contaminated sediments, chemicals seep into the material, making it hard to detect, and the effects persist long after the initial contamination event.
Historical Contamination and Liability
Chapter 2 of 4
🔒 Unlock Audio Chapter
Sign up and enroll to access the full audio experience
Chapter Content
Historically contaminated sites can pose significant legal and financial responsibilities. Many contaminants may have been introduced to environments decades ago when regulations were not as stringent, leading to complex questions about accountability and cleanup obligations.
Detailed Explanation
This chunk focuses on the implications of historical contamination. When a site was contaminated many years ago, the responsible parties may no longer be in operation or may be difficult to identify. This raises legal questions about who is liable for cleanup costs and environmental rehabilitation. It highlights the challenges authorities face in addressing pollution that stems from actions taken long before regulations were established.
Examples & Analogies
Consider a factory that operated 50 years ago and dumped waste into a river without any laws prohibiting such practices. The factory has since closed. Now, the river shows high levels of pollution affecting local communities. The question arises: who pays for cleaning up the pollution? This is similar to cleaning up a playground that was left in disarray by children playing years ago. While the children are no longer around, the mess remains, raising questions about responsibility for restoring the playground.
The Invisible Nature of Sediment Contamination
Chapter 3 of 4
🔒 Unlock Audio Chapter
Sign up and enroll to access the full audio experience
Chapter Content
Contamination is often not visible, leading to a delayed recognition of pollution's effects, such as high contaminants in fish and other aquatic life, which may only be discovered after significant harm has occurred.
Detailed Explanation
In this chunk, the text explains how contaminated sediments can remain hidden beneath the surface of the water, making it difficult for people to notice the pollution until it manifests as a problem, such as toxic fish caught for consumption. This ‘invisible problem’ can mislead individuals into thinking the environment is clean, thereby delaying necessary intervention and remediation efforts.
Examples & Analogies
Think about icebergs; the part visible above water is only a small fraction of the entire structure. Just as most of an iceberg lies below the surface, many environmental issues result from hidden contaminants in sediments that remain unnoticed until they harm fish populations or enter the food chain. This analogy illustrates how unseen dangers can significantly impact the ecosystem and public health.
Modeling Contamination Flux
Chapter 4 of 4
🔒 Unlock Audio Chapter
Sign up and enroll to access the full audio experience
Chapter Content
To address contamination from sediments, methods to model the flux of contaminants into the water must be developed, taking into account the concentration gradient between the sediment and the water.
Detailed Explanation
The text discusses the necessity of developing models to understand how contaminants transfer from sediments to water. The flux, or flow of contaminants, is based on the differences in concentration between the two mediums. Understanding this process is crucial for assessing the impact of contaminants and creating effective cleanup strategies.
Examples & Analogies
Imagine a sponge placed in a bowl of colored water. Over time, the sponge absorbs color from the water, and the color fades away from the bowl. The speed and extent of color change in both the sponge and the water depend on how much water is absorbed. Similarly, scientists model pollutant flux to understand contamination dynamics, determining how long it takes for the pollution to affect the surrounding water, guiding remediation efforts.
Key Concepts
-
D NAPL and L NAPL: Definitions and behaviors in sediment systems.
-
Mechanisms of contamination: How dissolution and diffusion occur.
-
Historical liability: Challenges in responsible party accountability.
Examples & Applications
When a factory discharges waste oils into a river, the resultant LNAPL will float, affecting surface water.
In a historic mining site, historical DNAPL contamination can still pose risks decades after operations ceased.
Memory Aids
Interactive tools to help you remember key concepts
Rhymes
Floats on top, sinks below, NAPLs move where waters flow.
Stories
Once upon a time, a factory dumped its oil waste in a river. The lighter oil floated, while the denser sludge sank, forever changing the waters they occupied.
Memory Tools
D for Dense, L for Light - remember NAPLs in the sight.
Acronyms
H-L-C
Historical Liability Challenges.
Flash Cards
Glossary
- D NAPL
Dense non-aqueous phase liquid, a type of contaminant that sinks in water.
- L NAPL
Light non-aqueous phase liquid, a type of contaminant that floats on water.
- Contamination Plume
Area in which contaminants are spread out due to diffusion.
- Mass Transfer
Movement of contaminants between sediment and water.
- Historical Liability
Responsibility for past contamination, especially when responsible parties no longer exist.
Reference links
Supplementary resources to enhance your learning experience.
